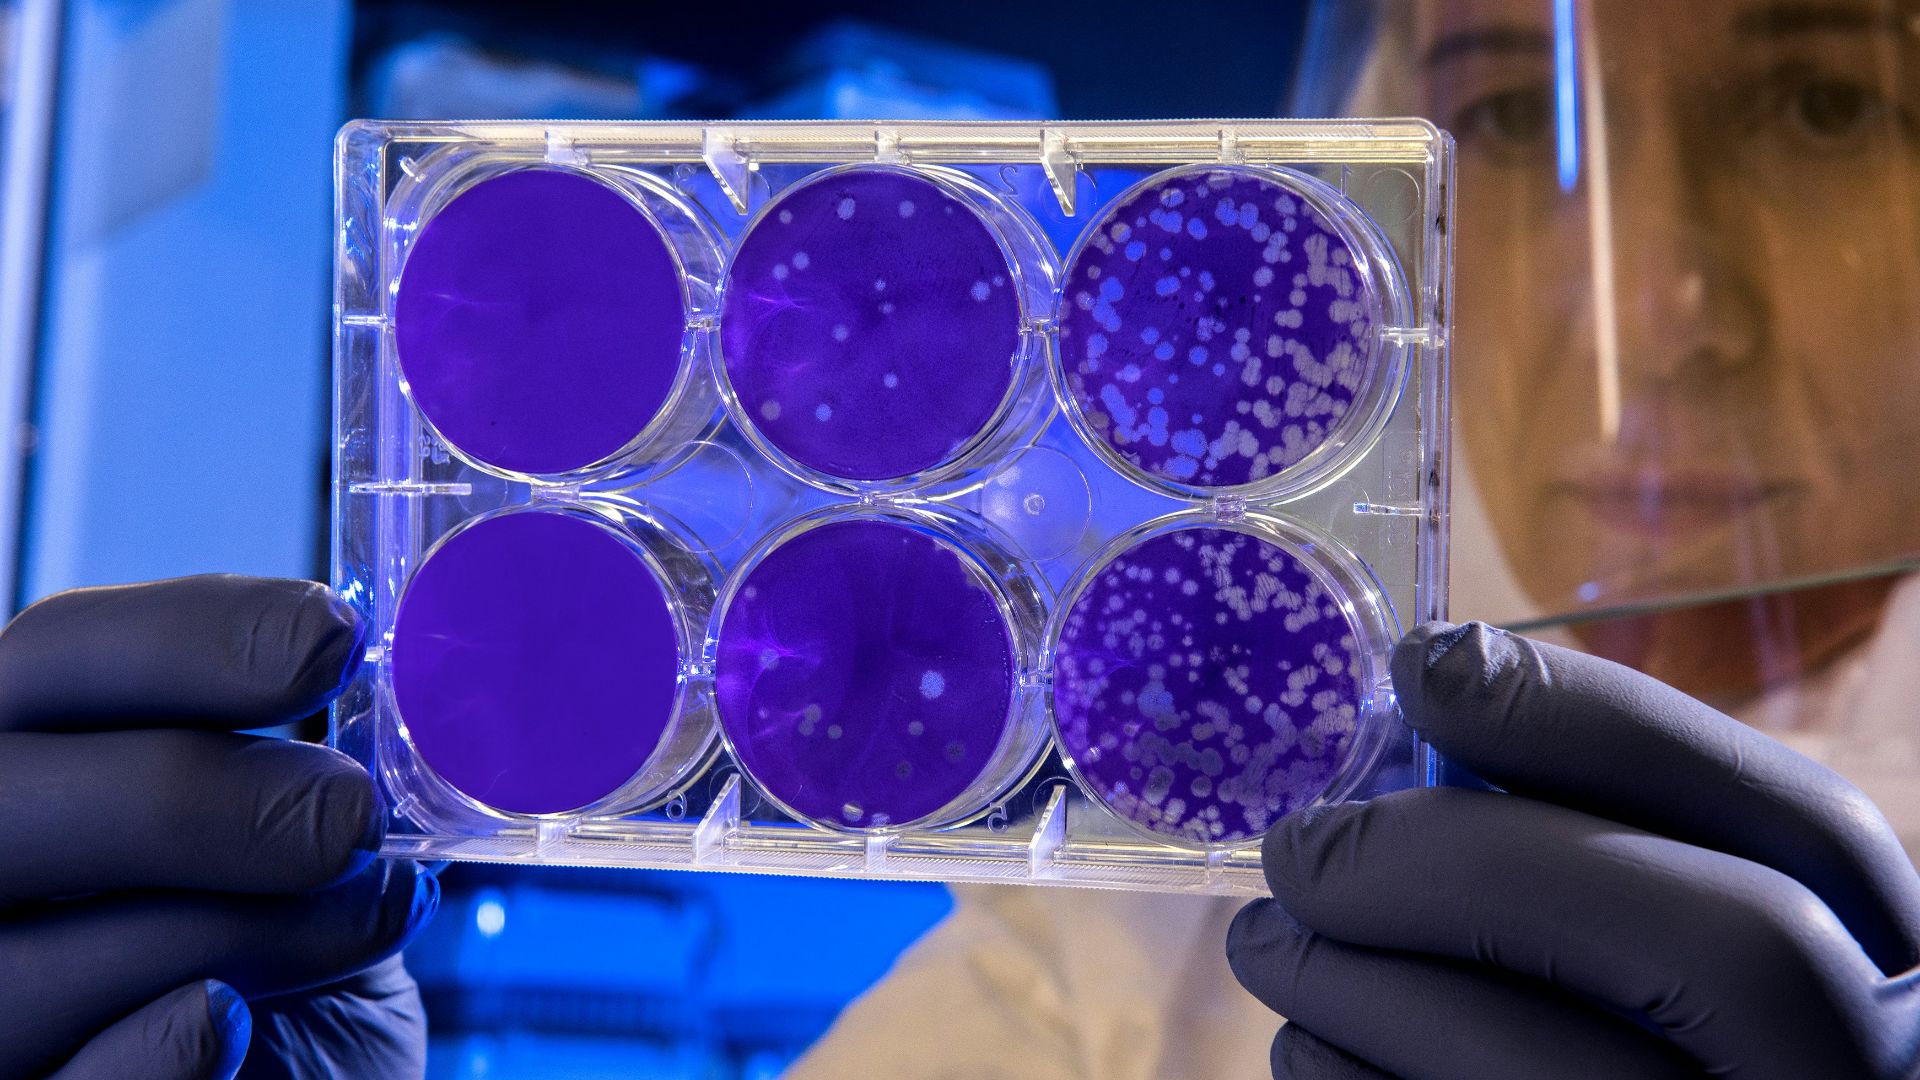
woman holding laboratory appratus

One Family Tree
Life feels wildly diverse, yet biology keeps pointing back to one shared beginning. New genetic research has pushed that origin much deeper into Earth’s past than scientists once assumed. This story follows how researchers traced every branch of life to the same root and why that ancient ancestor changes how we understand evolution itself.
The Idea That Shook Biology
For decades, evidence has pointed to a shared origin for every organism on Earth. Genetic similarities across bacteria, plants, animals, and fungi support the conclusion that all known life traces back to a single ancestral lineage that existed early in Earth’s history.
Luca Galuzzi (Lucag), Wikimedia Commons
What Scientists Mean by a Single Ancestor
The common ancestor refers to a population of early organisms, not one individual cell. Scientists call this ancestor LUCA, short for Last Universal Common Ancestor. It represents the most recent point where all current life forms still shared the same biological heritage.
Charles Darwin, Wikimedia Commons
LUCA Was Not the First Living Thing
LUCA emerged after earlier forms of life had already appeared and disappeared. It survived while other early lineages failed. This makes LUCA a successful descendant of earlier biological experiments rather than the original starting point of life on Earth.
How Old Scientists Once Thought LUCA Was
Earlier estimates placed LUCA closer to the emergence of complex life. These timelines relied on limited genetic data and simpler evolutionary models. For years, they framed LUCA as relatively recent within Earth’s long biological history.
What Pushed LUCA Further Back in Time
Improved genetic analysis revealed ancient molecular features shared by all life. Such discoveries forced scientists to revise earlier assumptions. The new evidence points to LUCA existing much earlier than once believed, closer to the period when Earth itself was still stabilizing.
Genetic Clues Shared by All Life
Every known organism relies on a core set of genes involved in reading, copying, and translating genetic information. These genes operate in nearly identical ways across life forms. Their universality points to inheritance from a shared ancestral source rather than independent origins.
Why These Shared Genes Matter
The genes common to all life control fundamental cellular processes. Because such systems are complex, they likely evolved once and were passed down. The persistence across billions of years supports the idea that modern diversity grew from a single biological framework.
How Scientists Reconstructed an Invisible Organism
LUCA left no fossils. Researchers inferred its traits by comparing genomes across living species. By identifying genes present in all branches of life, scientists reconstructed features that must have existed in the ancestor they all share.
History's most fascinating stories and darkest secrets, delivered to your inbox daily.
What LUCA Was Like at the Cellular Level
Evidence indicates LUCA had a membrane, enzymes, and genetic machinery similar to modern cells. It could store information and carry out metabolism. These traits show that early life had already reached a level of organization beyond simple chemical systems.
Where LUCA Likely Lived
Genetic evidence points to survival in environments rich in heat and chemical energy. Many shared enzymes function well under high temperatures. This suggests LUCA lived in conditions unlike Earth’s surface today, possibly deep underwater, where energy remained stable.
Why Hydrothermal Vents Matter
Deep-sea hydrothermal vents provide heat, minerals, and chemical gradients useful for early metabolism. Many features reconstructed for LUCA align with vent conditions. These environments offer a stable setting where early life could persist without sunlight or oxygen.
MARUM − Zentrum fur Marine Umweltwissenschaften, Universitat Bremen, Wikimedia Commons
Life Before Oxygen
LUCA existed long before oxygen accumulated in Earth’s atmosphere. Its metabolism likely relied on chemical reactions that did not involve oxygen. This fits geological evidence showing early Earth supported anaerobic life forms for hundreds of millions of years.
How LUCA Stored and Passed Information
LUCA used genetic material to store instructions and pass them on during reproduction. Shared molecular machinery across life forms shows that basic inheritance systems were already established. This allowed biological information to remain stable while still permitting gradual evolutionary change.
Why Early Life Was Already Complex
Although ancient, LUCA was not biologically simple. The genetic systems traced back to it involve multiple coordinated components. Such complexity indicates that substantial evolution occurred before LUCA appeared, reshaping ideas about how quickly life developed after Earth formed.
The First Major Split in Life’s History
Soon after LUCA, life diverged into two major domains, bacteria and archaea. Genetic differences between them run deep. This early split set separate evolutionary paths that later produced the diversity of life seen today.
Wing-Chi Poon, Wikimedia Commons
Where Eukaryotes Enter the Story
Plants, animals, and fungi belong to a group called eukaryotes, which appeared much later than LUCA. Their cells contain nuclei and complex structures absent in early life. Such evidence shows eukaryotes evolved after bacteria and archaea had already diversified.
What This Means for Evolutionary History
A very early common ancestor compresses the timeline for later diversification. Life did not crawl forward slowly at first. Instead, once basic cellular systems existed, evolution accelerated, producing major branches relatively quickly within Earth’s early history.
Why This Changes Origin-of-Life Models
If LUCA lived earlier than assumed, the transition from chemistry to biology must have happened rapidly. This challenges models that require long delays before stable life emerges and favors scenarios where early Earth conditions supported fast biological organization.
How Scientists Avoid Overstating the Evidence
Researchers separate what genetic data shows from what it cannot confirm. Reconstructions rely on shared genes, not direct observation. Therefore, conclusions remain bounded by uncertainty, with claims revised as methods improve or new data becomes available.
Why Dating Early Life Remains Difficult
Fossils rarely preserve organisms this old, and genetic clocks rely on assumptions that can shift results. Scientists combine geology, chemistry, and biology to estimate timelines. Even then, age ranges remain broad rather than fixed to precise dates.
National Institute of Allergy and Infectious Diseases, Unsplash
Why Early Earth Was Ready for Life
During LUCA’s era, Earth had liquid water and chemical energy sources with an active geology. These factors created stable environments where early organisms could survive. The planet became biologically active soon after conditions stopped being openly hostile to life.
How This Affects the Search for Life Beyond Earth
If life emerged quickly on early Earth, similar conditions elsewhere could also support biology. Scientists studying Mars, icy moons, and exoplanets use LUCA-based models to identify chemical environments where life might arise without long delays.
What This Discovery Does Not Claim
The existence of LUCA does not explain how life first began. It also does not identify a single organism or location. Instead, it marks the last shared point in a much earlier and more complex biological history.
Why the Single Ancestor Idea Still Holds
Despite debate over details, genetic evidence consistently points to one shared lineage behind all modern life. Alternative models involving multiple independent origins fail to explain the deep molecular similarities found across every major branch of biology.
National Cancer Institute, Unsplash
Why This Reshapes Humanity’s Place in Nature
Humans belong to the same continuous lineage as microbes, plants, and animals. Recognizing a shared ancestor emphasizes biological connection rather than separation. Therefore, life’s history becomes a single extended story, not a collection of unrelated beginnings.
Christopher Campbell, Unsplash